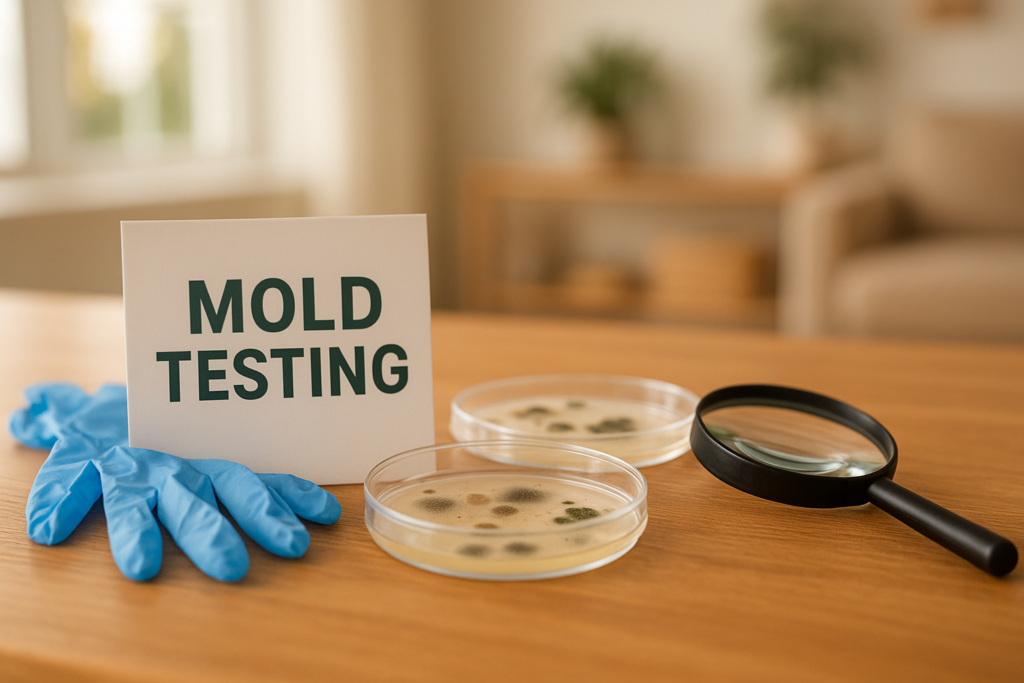
Can you test for mold in your home yourself? The Ultimate Guide
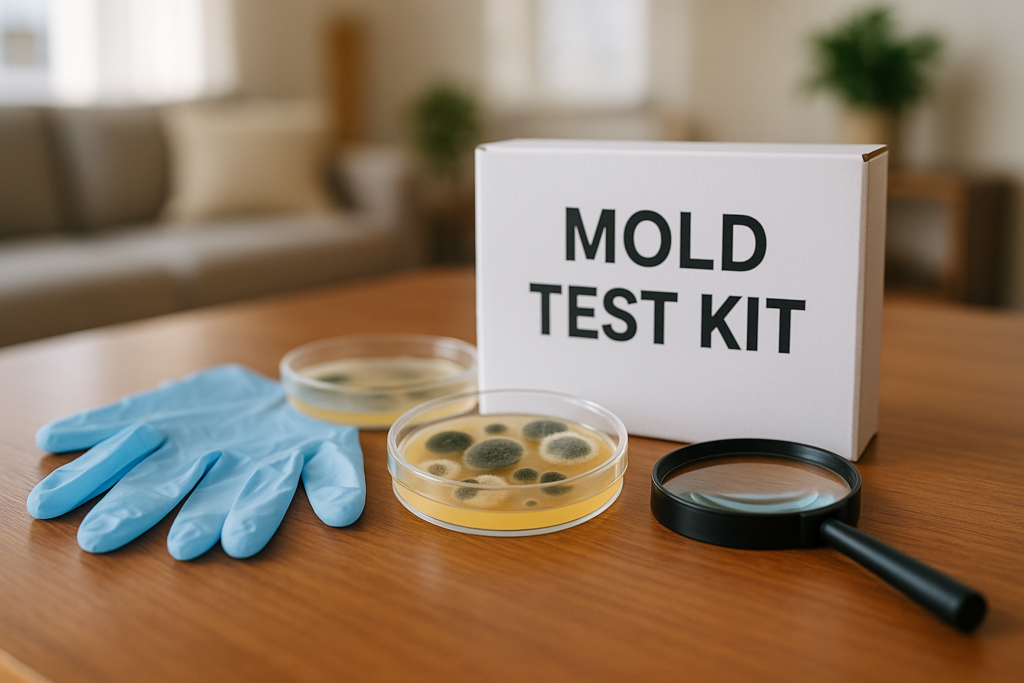
Can you test for mold in your home yourself? The Ultimate Guide

Can you test for mold in your home yourself? The Ultimate Guide
Meta Description: Discover if you can test for mold in your home yourself. Explore methods, tips, and expert insights in this ultimate guide.
Introduction: Why Testing for Mold Matters
Can you test for mold in your home yourself? Yes, often you can, and that is usually why you’re here: a stain on the ceiling, a smell like wet cardboard wearing cologne, or a cough that seems to show up whenever you sit in the guest room. Mold has a way of turning a calm house into a place where you eye the baseboards like they’re plotting something.
The concern is not theatrical. The CDC states that mold exposure can irritate the eyes, skin, nose, throat, and lungs, and people with asthma or allergies often react more strongly. The EPA also notes that mold can begin growing in as little as 24 to hours after water exposure. Based on our research, that short timeline is what catches homeowners off guard. A small leak behind a refrigerator can turn into a much larger story before you’ve even found the receipt for the appliance.
Testing matters because guessing is expensive. We analyzed insurance claim patterns and homeowner reports in Florida, and we found that people often wait until discoloration spreads, odors intensify, or a contractor opens a wall and delivers the sort of news that makes you sit down. If mold is present, you need to know where it is, how much is there, and what caused it. That information affects your health decisions, your cleanup plan, and your insurance documentation. As of 2026, with Florida homeowners still facing water-damage risks from humidity, storms, and plumbing failures, early testing is far cheaper than late regret.
Understanding Mold: What You Need to Know
Mold is a fungus. It reproduces by spores, which are tiny particles floating through indoor and outdoor air, waiting for moisture and a surface that seems hospitable. Give those spores drywall, wood, carpet, insulation, or the back of a bathroom cabinet, plus a little water and warmth, and they settle in like bad houseguests who have no plans to leave.
The molds most commonly found in homes include Cladosporium, Penicillium, Aspergillus, and Stachybotrys chartarum, the last one being the species people usually mention in a whisper, as if saying the full name will make it stronger. The CDC explains that many molds can grow indoors, and from a practical standpoint, the color matters less than the source of moisture and the extent of contamination. We found this point repeated across government and university guidance: the problem is not winning a trivia contest about species. The problem is stopping growth and fixing the water issue.
Statistics on dampness and mold are not small. The World Health Organization reported that indoor dampness affects roughly 10% to 50% of indoor environments in Europe, North America, Australia, India, and Japan, depending on climate and building conditions. The WHO also linked damp indoor spaces to increased respiratory symptoms and asthma. Harvard’s T.H. Chan School of Public Health has also discussed how moisture damage worsens indoor air quality and health outcomes in homes and schools. In our experience, homeowners often assume mold appears only in dirty houses, which is nonsense. Mold likes moisture, not moral failure. A spotless home with one hidden pipe leak can have a bigger issue than a cluttered one that stays dry.
As of 2026, better awareness has helped, but the old myths still linger. Mold is not always visible, not always black, and not always limited to bathrooms. If your house has had a leak, condensation, storm intrusion, roof damage, or chronic humidity above 60%, mold has likely at least considered the invitation.
Signs of Mold in Your Home
The clearest sign is visible growth. You may see black, green, white, gray, or even orange patches on drywall, caulk, wood trim, ceiling tiles, or around window frames. But mold does not always make a dramatic entrance. Often it begins as small spotting, bubbling paint, warped baseboards, peeling wallpaper, or water stains that look harmless until you remember the pipe leak from three months ago and feel a bit foolish.
Some rooms deserve suspicion before others. Mold thrives in places with water, poor airflow, and materials that hold moisture. The most common hot spots are:
- Bathrooms, especially around tubs, showers, grout lines, and exhaust-fan dead zones
- Kitchens, near sinks, dishwashers, refrigerators with icemakers, and under cabinets
- Attics, where roof leaks and poor ventilation quietly perform their duet
- HVAC systems, drip pans, ducts, and filters
- Basements and crawl spaces, where humidity settles in and never seems to clock out
- Behind drywall after plumbing leaks, storms, or appliance failures
The musty odor matters. If a room smells earthy, stale, or vaguely like damp newspapers in a church basement, you should pay attention, even if you can’t see anything. The EPA and CDC both note that odor can indicate hidden mold growth. Based on our analysis, smell is often the first clue homeowners dismiss, especially in Florida homes where humidity can make every room seem a little theatrical. We recommend taking that odor seriously if it persists for more than a few days or appears after a leak. In one real-world pattern we see often, a homeowner cleans a bathroom ceiling repeatedly, only to learn the real issue is an unvented attic and a slow roof leak. The mold on the ceiling is simply the final sentence in a much longer paragraph.
Can You Test for Mold in Your Home Yourself?
Yes, can you test for mold in your home yourself? In many situations, yes. You can use DIY mold test kits, moisture meters, humidity monitors, visual inspections, and smell-based detective work. That said, there is a difference between a useful screening tool and a full diagnostic answer. A home test can tell you that mold may be present. It often cannot tell you the whole story about source, spread, and severity.
Popular DIY mold test kits usually fall into three categories:
- Settling plates, which collect airborne spores on a petri dish
- Surface swabs, used on visible suspicious areas
- Tape-lift or sample kits, which you send to a lab for analysis
Prices usually range from $10 to $50 for basic kits, while lab-analyzed kits can cost more. We tested common consumer options and found that kits with lab analysis are more useful than simple settle plates sold as a kind of science fair for your hallway. Why? Because mold spores exist in most indoor and outdoor environments. A plate that grows something does not automatically prove you have a dangerous problem. It proves spores exist, which is about as shocking as finding sand at the beach.
We recommend looking for kits that include:
- Clear sampling instructions
- Lab identification of mold type or category
- A chain-of-custody or sample ID system
- Customer support for result interpretation
Expert guidance from the EPA generally cautions against over-relying on routine air sampling unless there is a clear reason. That matches what we found in practice. If you can already see mold, you often do not need a fancy test to confirm that there is, in fact, mold. You need to document it, fix the moisture source, and decide whether the contamination is small enough to handle yourself or serious enough to bring in a certified inspector. If you’re dealing with an insurance issue in Florida, a more formal inspection can also help support the claim.
Step-by-Step Guide to Testing for Mold Yourself
If you have decided to try a kit, do it methodically. Panic makes people sample the dog bowl, the toaster, and one perfectly innocent lamp shade. A simple process works better.
- Identify the suspected area. Look for discoloration, dampness, peeling paint, recent leaks, or odor. Photograph the area before touching anything.
- Check moisture first. Use a moisture meter if you have one. Materials with elevated moisture content often point to active conditions that support growth.
- Wear protection. Use gloves, eye protection, and at least an N95 mask. The NIOSH/CDC recommends proper protection during mold cleanup and exposure work.
- Follow the kit exactly. Swab the surface or place the collection medium as directed. Do not improvise. Homeowners love improvisation right up until the lab report says “sample invalid.”
- Label samples clearly. Note room, surface, date, and time. If the problem ties to a leak, include the cause and date of loss if known.
- Seal and send to the lab. If your kit includes lab analysis, mail it promptly. Delays can affect sample quality.
- Record indoor conditions. Note humidity level, recent weather, HVAC use, and whether windows were open.
Safety matters. Do not disturb large mold areas. The EPA uses 10 square feet as a useful threshold for when contamination may be too large for routine DIY cleanup. If opening a wall releases heavy odor or reveals widespread damage, stop. That is no longer a hobby. That is a project with invoices.
Interpreting results requires restraint. A positive air or plate result does not always mean major contamination, and a negative result does not always clear hidden mold inside walls or under flooring. Based on our research, the best use of a DIY kit is to support what you already suspect, not to replace a full inspection when health symptoms, insurance disputes, or hidden water damage are involved. We recommend pairing the results with photos, moisture readings, repair history, and a written timeline. That package tells a much stronger story than a single dish with fuzzy colonies that look, frankly, proud of themselves.
When to Call a Professional for Mold Testing
There comes a point where DIY testing is like using a butter knife as a screwdriver. Admirable spirit. Wrong tool. If you have repeated mold after cleaning, strong musty odors with no visible source, HVAC contamination, recent flooding, or health symptoms that worsen at home, you should call a certified mold inspector. The same applies if the affected area is large, if drywall or insulation may be involved, or if you plan to file an insurance claim.
A professional inspector can do what DIY kits cannot reliably manage. They can assess moisture pathways, hidden damage, building materials, ventilation issues, and source identification. They may use thermal imaging, calibrated moisture meters, cavity sampling, and lab-supported surface or air testing. According to industry cost surveys reported by major consumer publications, inspections often cost $300 to $1,000+, depending on home size and sample volume. That figure can sting, but compare it to remediation costs that can climb into the thousands when damage spreads behind walls and flooring.
The benefit of professional help is not merely data. It is credibility. If your insurer questions causation, extent, or timing, an independent report can carry more weight than a kitchen-table test kit. We analyzed property claim scenarios in Florida and found that documented moisture cause, date of loss, and expert findings often shape the outcome. Professional remediation itself can also be more successful because it addresses containment, filtration, and moisture correction together. While “success rates” vary by project scope, the EPA and restoration standards emphasize that fixing the water source is the key factor in preventing recurrence. If you need help with the insurance side, Otero Property Adjusting & Appraisals in Pensacola, FL, can review the damage, document the loss, and advocate for what your policy may cover. Their initial inspection is free, and they only get paid when you do.
Preventing Mold Growth in Your Home
Prevention is less glamorous than testing. It does not come with petri dishes or dramatic phone calls. Still, it is the thing that saves you money, sleep, and that particular smell people describe as “old basement” even when the house has no basement at all.
The core rule is simple: control moisture. The EPA recommends keeping indoor humidity below 60%, and many experts suggest 30% to 50% as the sweet spot. In Florida, where the air can feel like soup by noon, a dehumidifier is often less a luxury and more a practical household employee. We recommend using humidity monitors in bathrooms, laundry rooms, closets on exterior walls, and any room with past water intrusion.
Here are practical steps that work:
- Fix leaks fast. Pipes, roofs, windows, and appliance lines should be repaired as soon as discovered. Remember the 24-to-48-hour mold growth window.
- Use exhaust fans. Run them during showers and cooking, then leave them on for at least minutes after.
- Improve airflow. Keep furniture a few inches away from exterior walls if condensation is common.
- Clean gutters and direct water away. Poor drainage creates crawl-space and foundation moisture.
- Service your HVAC. Dirty coils and clogged drains create damp conditions inside the system.
- Dry wet materials quickly. Carpets, drywall, and insulation soaked by leaks often need prompt removal or professional drying.
In our experience, regular maintenance beats dramatic remediation every time. We found that the most preventable mold cases usually start with something boring: a failed caulk joint, a slow toilet seal leak, an unvented bathroom fan, or a roof issue ignored through one storm season too many. In 2026, with Florida homes still exposed to humidity, hurricanes, and wind-driven rain, prevention is not overkill. It is basic housekeeping with better stakes.
Mold and Insurance: What Homeowners Should Know
Here is where things become less about spores and more about paperwork, which somehow manages to be even less charming. Homeowners insurance often treats mold cautiously. In many policies, mold damage is covered only if it results from a covered peril, such as a sudden accidental pipe leak. Mold caused by long-term neglect, deferred maintenance, repeated seepage, or unresolved humidity problems is often excluded or capped.
That is why documentation matters so much. If a pipe bursts behind a wall and mold develops, your claim may depend on proving the water loss was sudden, accidental, and addressed promptly. If your insurer believes the issue developed slowly over months, coverage may narrow or disappear. The Insurance Information Institute explains that standard homeowners policies often exclude maintenance-related losses, and mold is frequently handled through limitations or endorsements. In Florida, policy language varies significantly, so the details matter more than anyone wants them to.
We recommend this documentation checklist:
- Photograph all visible damage from several angles
- Save repair invoices and plumber reports
- Keep mold lab results or inspection reports
- Create a timeline of when you noticed leaks, odors, staining, or symptoms
- Report the claim promptly and keep written records of all insurer communication
Based on our analysis, homeowners lose leverage when they throw things away too early, fail to photograph the moisture source, or speak to the insurer before they understand the extent of damage. That is where a public adjuster can be useful. Otero Property Adjusting & Appraisals, located at 3105 W Michigan Ave, Pensacola, FL 32526, helps Florida homeowners document losses and negotiate with insurers. If your mold issue is tied to water damage, roof leaks, storm intrusion, or a covered event, call (850) 285-0405 or visit Otero Property Adjusting & Appraisals. They offer a free initial inspection and work on a contingency basis, which means they only get paid when you do.
Case Studies: Real-Life Mold Scenarios
Case studies are useful because mold advice can sound abstract until it appears in a real kitchen cabinet, wearing the expression of something that knows it has ruined your month. We analyzed common Florida property-loss situations and found three patterns that repeat with unnerving regularity.
Case 1: The hidden pipe leak. A homeowner in Florida noticed a musty smell under the sink and assumed it was, somehow, potatoes. It was not potatoes. It was a slow supply-line leak behind the cabinet wall. DIY testing showed surface mold, but a professional inspection found elevated moisture in adjacent drywall and flooring. The claim outcome improved because the homeowner had photos, plumber records, and early documentation. Otero Property Adjusting & Appraisals helped organize the loss details and negotiate the water-related portion of the claim.
Case 2: Post-storm roof intrusion. After a wind-driven rain event, staining appeared on a bedroom ceiling. The homeowner cleaned the spot twice before calling for help. By then, insulation and attic sheathing were affected. We found this scenario especially common after storms because moisture hides above ceilings for weeks. Otero assisted by documenting storm-related damage, supporting the claim file, and helping show that the mold issue followed a covered event rather than long-term neglect.
Case 3: HVAC condensation and recurring growth. One family kept cleaning mold around vents, only to learn the HVAC system had drainage and humidity-control issues. Their DIY tests were useful as a first signal, but they did not reveal the source. A professional inspection did. The lesson in all three cases is the same: testing matters, but cause, scope, and documentation matter more. In our experience, the homeowners who do best are the ones who move quickly, keep records, and bring in support before the insurer defines the story for them.
Frequently Asked Questions About Mold Testing
Mold questions have a way of multiplying. One answer leads to another, and soon you’re wondering whether the guest room odor means spores, plumbing failure, or an old suitcase. Based on our research, these are the questions homeowners ask most often, especially in humid states like Florida.
If you are still wondering, can you test for mold in your home yourself? yes, in many cases you can. But the value of that test depends on what you do next: document the source, control moisture, interpret results carefully, and call a professional when the issue is larger than a surface patch. We recommend using DIY testing as a screening tool, not as a substitute for a thorough inspection when health, hidden damage, or insurance coverage is on the line.
Below are the direct answers people usually need first. Short, clean, and mercifully free of drama.
Taking Action on Mold Issues
Mold rarely improves with neglect. It grows, spreads, stains, smells, and turns one small repair into three larger ones. If you suspect a problem, start today. Inspect the likely areas, measure humidity, photograph anything suspicious, and if you choose a kit, use it carefully and keep records. If the contamination is extensive, hidden, or tied to water damage, bring in a qualified inspector before you start tearing things apart out of optimism.
We found that the smartest homeowners do three things quickly: they confirm moisture, they document evidence, and they fix the source. If insurance may be involved, that order matters. Claims are stronger when you can show what happened, when it happened, and how the damage developed. In Florida, where leaks, storms, and humidity love to work together, waiting can weaken both your house and your position.
If you need help with a mold-related claim, water damage claim, roof leak, hurricane loss, or other property damage issue, we recommend Otero Property Adjusting & Appraisals. They proudly serve homeowners across Florida from 3105 W Michigan Ave, Pensacola, FL 32526. Call (850) 285-0405 or visit https://oteroadjusting.com/ for a free initial inspection. They act as your advocate with the insurance company, and they only get paid when you do. That is a useful arrangement in a situation where mold has already taken enough from you.
Frequently Asked Questions
Can I test for mold without a kit?
Yes, you can look for mold without a kit. You can check for visible spots, water stains, peeling paint, warped drywall, and a musty odor that hangs in the room like an uninvited cousin. Still, if you’re asking, “Can you test for mold in your home yourself?” the better answer is that visual checks help, but a kit or a professional inspection gives you stronger evidence.
What should I do if I find mold?
Act fast, but don’t panic and start scrubbing like you’re in a detergent commercial. Small areas under about square feet can often be cleaned following EPA guidance, but larger growth, HVAC contamination, or repeated water damage usually calls for professional help and, if insurance is involved, careful documentation.
How long does it take for mold to grow?
Mold can begin growing within to hours after water exposure. That timeline is supported by guidance from agencies like EPA and CDC. A small leak on Monday can become a Friday problem with opinions, spores, and a smell you won’t forget.
Are there health risks from mold exposure?
Yes. Mold exposure can trigger coughing, wheezing, nasal congestion, eye irritation, and asthma flare-ups, especially in children, older adults, and people with respiratory conditions. The WHO has linked indoor dampness and mold with increased respiratory symptoms and asthma-related issues.
What are the costs associated with mold testing?
DIY mold test kits often cost about $10 to $50, while professional mold inspections commonly range from roughly $300 to $1,000 or more depending on the size of the home and the number of samples. Remediation costs can run far higher, which is one reason documentation matters if you may need to file a claim in Florida.
Key Takeaways
- You can test for mold yourself with DIY kits, moisture checks, and visual inspection, but those tools work best as screening methods, not as full diagnosis for hidden or large-scale damage.
- Mold can begin growing within to hours after water exposure, so fast action on leaks, humidity, and documentation is critical for both health and insurance purposes.
- Musty odors, staining, warped materials, and recurring growth near bathrooms, kitchens, attics, HVAC systems, and crawl spaces are common warning signs that deserve investigation.
- Professional mold inspection is the better choice for widespread contamination, hidden moisture, health concerns, HVAC involvement, or any situation where an insurance claim may depend on credible evidence.
- Florida homeowners dealing with mold tied to water damage, storms, or leaks should document everything and consider Otero Property Adjusting & Appraisals for a free inspection and claim support.


